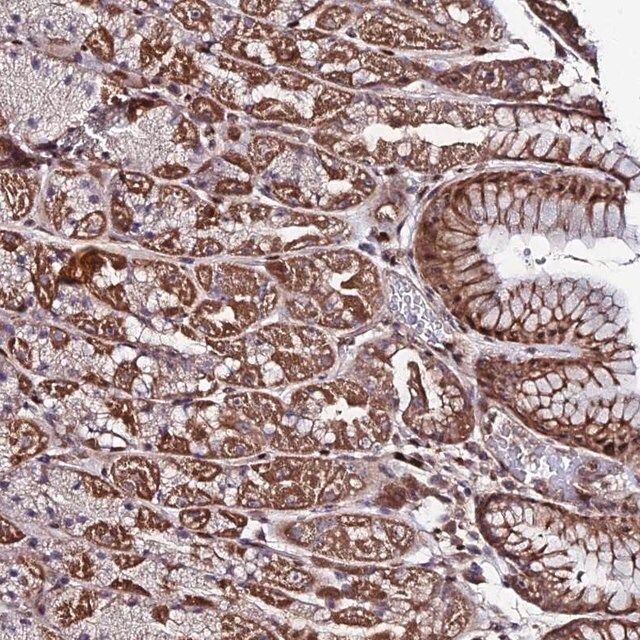

ФњЕФЮЛжУЃКЪзвГ > АыЕКbdЬхг§ЪжЛњПЭЛЇЖЫ
жааФ > Anti-AMER3 antibody produced in rabbit
АыЕКbdЬхг§ЪжЛњПЭЛЇЖЫ
жааФ
Anti-AMER3 antibody produced in rabbit
| АыЕКbdЬхг§ЪжЛњПЭЛЇЖЫ БрКХЃК | 3361218 |
| ЙцИёЃК | Prestige Antibodies® Powered by Atlas Antibodies, affinity isolated antibody, buffered aqueous glycerol solution |
| АќзАЙцИёЃК | 100 ІЬL |
| АыЕКbdЬхг§ЪжЛњПЭЛЇЖЫ РрБ№ЃК | НјПкЪдМС |
| ЦЗХЦЃК | Sigma-Aldrich |
| гХЛнМлЃК | СЂМДзЩбЏ |
АыЕКbdЬхг§ЪжЛњПЭЛЇЖЫ
МлИё
| АыЕКbdЬхг§ЪжЛњПЭЛЇЖЫ БрКХ | АќзАЕЅЮЛ | ЕЅМл(дЊ) | ЙњФкЯжЛѕ | ЙњЭтПтДц | бЏМлЕЅ |
| 3361218 | 100 ІЬL | 6380 |
АыЕКbdЬхг§ЪжЛњПЭЛЇЖЫ
Б№Ућ
Anti-AMER3 antibody produced in rabbit
Anti-FLJ38377
Anti-Family With Sequence Similarity 123C
ЛљБОаХЯЂ
| Human Protein Atlas NumberЁОШЫРрЕААзжЪЭМЦзБрКХЁП | HPA045593 Human Protein Atlas characterization data |
| ImmunogenЁОУтвпдЁП | family with sequence similarity 123C recombinant protein epitope signature tag (PrEST) |
| ApplicationЁОгІгУЁП | All Prestige Antibodies Powered by Atlas Antibodies are developed and validated by the Human Protein Atlas (HPA) project (www.proteinatlas.org)and as a result, are supported by the most extensive characterization in the industry. The Human Protein Atlas project can be subdivided into three efforts: Human Tissue Atlas, Cancer Atlas, and Human Cell Atlas. The antibodies that have been generated in support of the Tissue and Cancer Atlas projects have been tested by immunohistochemistry against hundreds of normal and disease tissues and through the recent efforts of the Human Cell Atlas project, many have been characterized by immunofluorescence to map the human proteome not only at the tissue level but now at the subcellular level. These images and the collection of this vast data set can be viewed on the Human Protein Atlas (HPA) site by clicking on the Image Gallery link. To view these protocols and other useful information about Prestige Antibodies and the HPA, visit sigma.com/prestige. |
| Features and BenefitsЁОЬиЕуКЭгХЪЦЁП | Prestige Antibodies® are highly characterized and extensively validated antibodies with the added benefit of all available characterization data for each target being accessible via the Human Protein Atlas portal linked just below the product name at the top of this page. The uniqueness and low cross-reactivity of the Prestige Antibodies® to other proteins are due to a thorough selection of antigen regions, affinity purification, and stringent selection. Prestige antigen controls are available for every corresponding Prestige Antibody and can be found in the linkage section. Every Prestige Antibody is tested in the following ways:
|
| LinkageЁОСЊЯЕЁП | Corresponding Antigen APREST83457. |
| Physical formЁОЭтаЮЁП | Solution in phosphate buffered saline, pH 7.2, containing 40% glycerol and 0.02% sodium azide. |
| Legal InformationЁОЗЈТЩаХЯЂЁП | Prestige Antibodies is a registered trademark of sigma-aldrich Co. LLC |
АыЕКbdЬхг§ЪжЛњПЭЛЇЖЫ
аджЪ
| biological sourceЁОЩњЮяРДдДЁП | rabbit |
| conjugateЁОХМСЊЮяЁП | unconjugated |
| antibody formЁОПЙЬхаЮЪНЁП | affinity isolated antibody |
| antibody product type | primary antibodies |
| cloneЁОПЫТЁЁП | polyclonal |
| product lineЁОАыЕКbdЬхг§ЪжЛњПЭЛЇЖЫ ЯпЁП | Prestige Antibodies® Powered by Atlas Antibodies |
| formЁОаЮЪНЁП | buffered aqueous glycerol solution |
| species reactivity | human |
| packagingЁОАќзАЁП | antibody small pack of 25 μL |
| technique(s) | immunofluorescence: 0.25-2 μg/mL immunohistochemistry: 1:50-1:200 |
| immunogen sequenceЁОУтвпдађСаЁП | YSASTQDQRCRDRVQDLSWLRVEPTGLGVQAWASVEDQPLQLSTEAVEQVAHGSQLDSEPRSAPAARWSSQGHHPESLGLTLNSQQEGGVSASAPEC |
| shipped inЁОдЫЪфЁП | wet ice |
| storage temp.ЁОДЂДцЮТЖШЁП | −20Ёц |
| Gene Information | human ... FAM123C(205147) |
АыЕКbdЬхг§ЪжЛњПЭЛЇЖЫ
ЫЕУї
| DisclaimerЁОУтд№ЩљУїЁП | Unless otherwise stated in our catalog or other company documentation accompanying the product(s), our products are intended for research use only and are not to be used for any other purpose, which includes but is not limited to, unauthorized commercial uses, in vitro diagnostic uses, ex vivo or in vivo therapeutic uses or any type of consumption or application to humans or animals. |
АВШЋаХЯЂ
| Storage Class CodeЁОДЂДцЗжРрДњТыЁП | 10 - Combustible liquids |
| WGK | WGK 1 |





